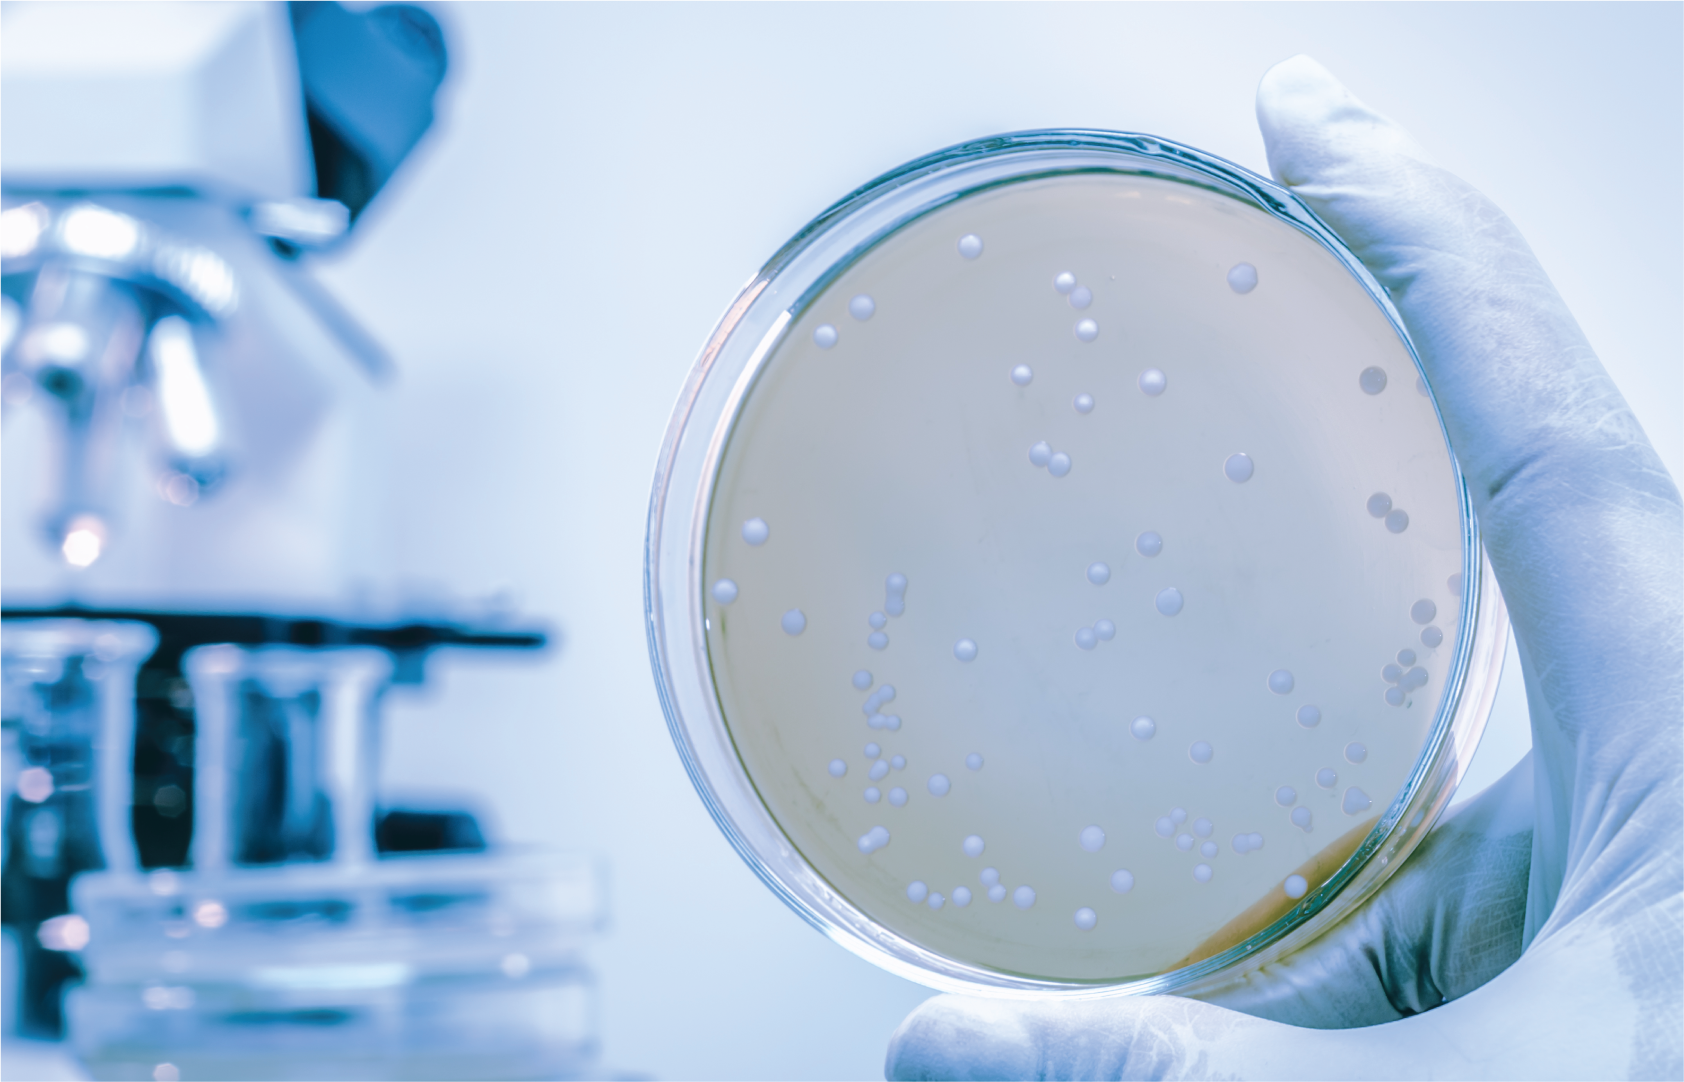

Agar Agar nutrients are :
-
Minerals: Agar agar powder is a good source of calcium and
iron. It contains other minerals as well, such as zinc and
potassium. Those are present in smaller amounts.
-
Vitamins: Small amounts of vitamin E and vitamin K are
present in agar agar powder. It is richest in folate, which
is also known as vitamin B9.
- Fiber: Agar Agar powder contains a significant amount of soluble dietary fiber.